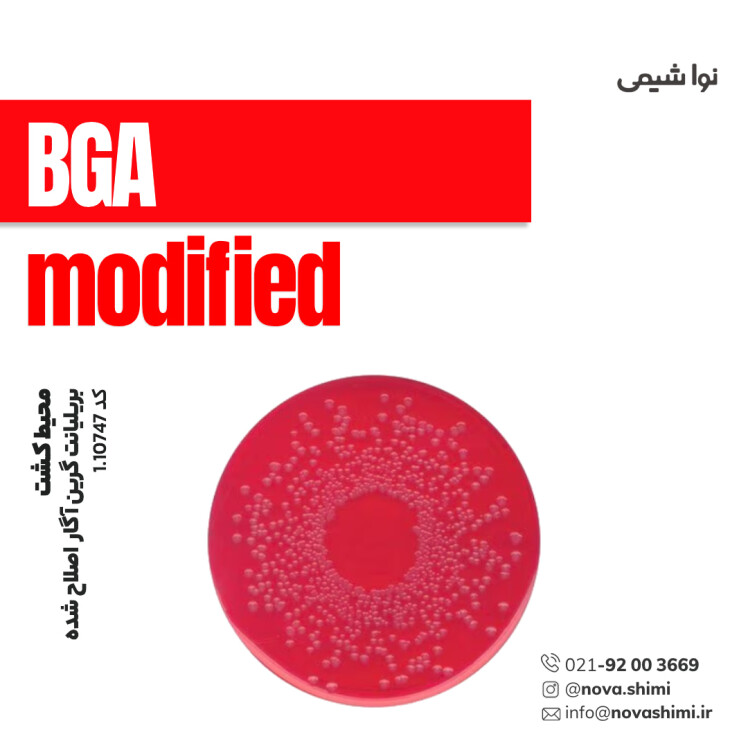
محیط کشت بریلیانت گرین آگار اصلاح شده (BGA agar, modified)

محیط کشت EC Broth مرک (EC (Escherichia coli) broth)
مشخصات فنی محیط کشت EC Broth:
1. برند: Merck Millipore
2. کاربرد: شناسایی و تأیید اشریشیا کلی (E. coli) در نمونههای آب و مواد غذایی.
3. فرم فیزیکی: گرانول(granular)
4. حجم بسته: ۵۰۰ گرم
محیط کشت ای سی براث چیست؟
ای سی براث یک محیط کشت مایع انتخابی است که برای تشخیص و شمارش باکتری اشرشیا کلی (E. coli) در نمونههای آب و مواد غذایی، تحت شرایط گرمدوست طراحی شده است. نُـواشیمی، به عنوان یکی از تامین کنندگان مواد آزمایشگاهی و محیط کشت برند مرک و سیگما آلدریچ، آماده ارائه خدمات فروش محیط کشت EC Broth مرک کد 1.10765به شما عزیزان خواهد بود. برای دریافت اطلاعات فنی و استعلام قیمت محیط کشت ای سی براث مرک، از طریق شماره 02192003669 با کارشناسان فروش نُـوا شیمی تماس حاصل فرمایید.
برای آشنایی بیشتر با ویژگیها و مشخصات محصول، میتوانید با کلیک روی هر عنوان، به توضیحات تکمیلی در زیرعنوانهای مربوطه دسترسی پیدا کنید.
مشخصات محصول (Product Specifications)
مشخصات فنی محیط کشت EC Broth مرک (Product Specifications)
در جدول زیر میتوانید مشخصات فنی محیط کشت ای سی براث مرک را مشاهده کنید.
ویژگی | توضیحات |
|---|---|
Appearance (ظاهر فیزیکی) | گرانولهای یکنواخت، بژ تا کرم، بدون کلوخه |
Color (رنگ) | بژ روشن |
pH-value (25°C, 37 g/L در آب، بعد از اتوکلاو) | 6.7 – 7.1 |
Form (فرم فیزیکی) | پودر گرانولار قابل حل در آب |
Solubility (قابلیت انحلال) | 74 g/L |
Growth Promotion Test (تست رشد) | رشد مطلوب ≥ 50٪ برای Escherichia coli ATCC 25922 و ATCC 8739 |
Selectivity (انتخابپذیری) | مهار رشد باکتریهای Gram مثبت و غیر کولونیزا؛ رشد تشویقی برای باکتریهای کوليفورم و E. coli |
Nutrient Sources (منابع غذایی) | لاکتوز (منبع انرژی و شاخص متابولیک)، عصاره مخمر (ویتامینهای گروه B)، بیل سالت (مهارکننده باکتریهای غیرهدف) |
Gas Formation (تولید گاز) | مثبت برای گونههای لاکتوز مثبت مانند E. coli |
Application (کاربرد آزمایشگاهی) | تغلیظ، شمارش و تأیید باکتریهای کوليفورم از مواد غذایی، خوراک دام و سایر نمونهها |
Storage Condition (شرایط نگهداری) | 15–25°C، محیط خشک، بستهبندی محکم |
برای مشاهده اطلاعات کامل محصول در سایت مرک و جزئیات کاربردی آن، بر روی EC Broth کلیک کنید. شرکت نُـوا شیمی، تأمینکننده انواع محیط کشت برندهای معتبر مانند مرک و سیگما آلدریچ است و امکان خرید آسان و مطمئن این محصولات آزمایشگاهی را برای شما فراهم میکند.
خرید محیط کشت EC Broth مرک (GranuCult® prime EC (Escherichia coli) broth)
خرید محیط کشت EC Broth مرک (GranuCult® prime EC (Escherichia coli) broth) کد 1.10765
محیط کشت ای سی براث (EC broth) یک محیط گرانولار و انتخابی است که برای تغلیظ، شمارش و تأیید باکتریهای کوليفورم، بهویژه Escherichia coli طراحی شده است. لاکتوز موجود در محیط رشد باکتریهای لاکتوز مثبت را تشویق میکند و بیل سالت رشد میکروارگانیسمهای غیرهدف، بهویژه Gram مثبتها، را مهار میکند. این محیط برای نمونهبرداری از مواد غذایی، خوراک دام و سایر نمونهها مناسب است و تولید گاز توسط باکتریهای لاکتوز مثبت امکان تشخیص اولیه E. coli را فراهم میکند. ترکیب غنی از مواد غذایی شامل عصاره مخمر و سایر منابع نیتروژنی باعث رشد سریع و مطمئن باکتریهای هدف میشود و فرمول گرانولار آن حل شدن سریع، یکنواختی و کاربری آسان در آزمایشگاه را تضمین میکند.
کمپانی مِرک (MERCK)
شرکت مرک (Merck KGaA) یکی از قدیمیترین و معتبرترین کمپانیهای علمی و فناوری در جهان است که در سال 1668 در آلمان تأسیس شد و امروزه بهعنوان پیشگام جهانی در حوزههای مواد شیمیایی آزمایشگاهی، بیوتکنولوژی و داروسازی شناخته میشود. بخش مواد آزمایشگاهی مرک، طیف گستردهای از مواد شیمیایی با گریدهای مختلف از جمله آنالیتیکال، ACS، HPLC، و Suprapur® را ارائه میدهد که برای تحقیقات علمی، کنترل کیفیت صنعتی، و مصارف آموزشی کاربرد دارند.
شرکت نُـوا شیمی، تامین کننده مواد آزمایشگاهی محیط کشت
شرکت نُـوا شیمی، با سابقهای درخشان در تامین مواد آزمایشگاهی، استاندارد ها و تجهیزات آزمایشگاه، با دسترسی گسترده به محصولات برندهای معتبر داخلی و بینالمللی، تامین نیازهای صنایع، آزمایشگاههای تحقیقاتی و داروسازی را با رویکردی مدرن و دقیق دنبال میکند. در صورت نیاز به استعلام قیمت محیط کشت ای سی براث مرک کد 1.10765یا سایر مواد آزمایشگاهی، استاندارد و رفرنسهای آزمایشگاهی کارشناسان ما از طریق خط ویژه 02192003669 آماده پاسخگویی و ارائه مشاوره تخصصی به شما خواهند بود.
آنالیز و کیفیت (Analysis Note)
ویژگیهای آنالیزی و کیفیت (Analysis Note)
Appearance (ظاهر فیزیکی): گرانول یکنواخت، بژ روشن تا کرم، بدون کلوخه
Color (رنگ): زرد کمرنگ تا زرد مایل به قهوهای
pH-value (25°C, 37 g/L in H₂O, بعد از اتوکلاو): 6.6 – 7.0
Form (فرم فیزیکی): پودر گرانولار قابل حل در آب
Growth Promotion Test (تست رشد میکروبی): رشد مؤثر ≥50٪ برای Escherichia coli ATCC 25922 و ATCC 8739
Selectivity (انتخابپذیری): مهار رشد Enterococcus faecalis و سایر میکروارگانیسمهای غیرهدف، رشد E. coli تشویق میشود
Nutrient Sources (منابع غذایی): تریپتون و عصاره مخمر برای تأمین نیتروژن و ویتامینها، لاکتوز به عنوان منبع کربن و انرژی
Gas Production (تولید گاز): E. coli لاکتوز مثبت گاز تولید میکند
Application (کاربرد): تغلیظ، شمارش و تأیید کوليفورمها و E. coli در مواد غذایی، خوراک دام و سایر نمونهها
Storage Condition (شرایط نگهداری): 15–25°C، محیط خشک
جدول راهنمای ویژگیهای آنالیزی محیط کشت GranuCult® prime EC Broth
ویژگی | توضیحات |
|---|---|
Appearance (ظاهر فیزیکی) | گرانول یکنواخت، بژ تا کرم، بدون کلوخه |
Color (رنگ) | زرد کمرنگ تا زرد مایل به قهوهای |
pH (25°C, 37 g/L) | 6.6 – 7.0، مناسب برای رشد باکتریهای هدف |
Form (فرم) | پودر گرانولار، سریع و یکنواخت حل میشود |
Growth Promotion Test | ≥50٪ بازیابی E. coli ATCC 25922 و ATCC 8739 |
Selectivity (انتخابپذیری) | مهار Enterococcus faecalis و سایر باکتریهای غیرهدف، رشد E. coli تشویق میشود |
Nutrient Sources | تریپتون، عصاره مخمر، لاکتوز، منابع نیتروژن و انرژی |
Gas Production | تولید گاز توسط باکتریهای لاکتوز مثبت |
Application (کاربرد) | تغلیظ، شمارش و تأیید کوليفورمها و E. coli در غذا و خوراک دام |
Storage Condition | 15–25°C، محیط خشک، دور از رطوبت |
کاربردهای محیط کشت EC Broth
مهمترین کاربردهای محیط کشت EC Broth:
در ادامه، کاربردهای محیط کشت EC Broth مرک را مطالعه خواهیم نمود:
1. تغلیظ کوليفورمها و E. coli: این محیط برای غنیسازی نمونههای غذایی، آب و خوراک دام طراحی شده تا تعداد باکتریهای هدف افزایش یابد و قابل شناسایی شوند.
2. شمارش و تأیید E. coli: استفاده در آزمونهای کنترل کیفیت مواد غذایی، لبنیات، آب آشامیدنی و سایر محصولات برای تشخیص و شمارش E. coli به عنوان شاخص آلودگی میکروبی.
3. انتخابپذیری بالا: به دلیل حضور نمکهای صفراوی، رشد باکتریهای غیرهدف مهار شده و رشد E. coli و کوليفورمها تشویق میشود، بنابراین دقت آزمایش افزایش مییابد.
4. تست تولید گاز: لاکتوز موجود در محیط به باکتریهای کوليفورم اجازه میدهد گاز تولید کنند که بهعنوان شاخص مثبت برای شناسایی E. coli استفاده میشود.
5. کاربرد در صنایع غذایی و محیط زیست: مناسب برای آزمایشهای کنترل کیفیت در صنایع غذایی، آب، لبنیات، نوشیدنیها و خوراک دام.
6. مطابقت با استانداردهای بینالمللی: استفاده در آزمونهای ISO 7251 و FDA-BAM برای تأیید عملکرد و قابل اعتماد بودن نتایج.
برای دریافت استعلام قیمت محیط کشت EC Broth مرک کد 1.10765، لطفا با شماره 02192003669 تماس حاصل فرمایید. کارشناسان ما آماده پاسخگویی به سوالات شما هستند.
نکات ایمنی
نکات ایمنی و نگهداری (Safety & Storage)
در ادامه نکات ایمنی استفاده از محیط کشت ای سی براث مرک (GranuCult® prime EC (Escherichia coli) broth) برند مرک را مطالعه خواهیم نمود:
ویژگی | توضیحات |
|---|---|
Pictograms (نشانههای هشدار) | GHS07 – علامت هشدار |
Signal Word (کلمه هشدار) | Warning – هشدار |
Hazard Statements (جملات مخاطرهآمیز) | H315: تحریک پوست H319: تحریک چشم H335: تحریک سیستم تنفسی |
Precautionary Statements (اقدامات پیشگیرانه) | P261: از استنشاق گرد و غبار خودداری شود P264: پس از تماس دستها شسته شود P271: در فضای تهویهشده استفاده شود P280: دستکش، ماسک و محافظ چشم استفاده شود P302+P352: در صورت تماس با پوست، شستشو با آب و صابون P305+P351+P338: در صورت تماس با چشم، شستشو با آب و برداشتن لنزها در صورت امکان |
Target Organs (اندامهای هدف) | سیستم تنفسی |
Storage Class Code (کد نگهداری) | 11 – جامدات قابل اشتعال |
WGK (کد خطر آب) | WGK 2 |
Personal Protective Equipment (تجهیزات حفاظتی) | ماسک گرد و غبار N95، دستکش، محافظ چشم |
اگر به دنبال محیط کشت EC Broth مرک (Escherichia coli) هستید، نُـوا شیمی همراهی مطمئن در مسیر تامین نیاز های شما خواهد بود. برای سفارش، دریافت مشاوره فنی و آگاهی از شرایط همکاری؛ از طریق شماره 02192003669 با تیم فروش در ارتباط باشید.
سوالات متداول (FAQ)
سوالات متداول درباره محیط کشت EC Broth:
1. EC براث برای چه نوع باکتریهایی مناسب است؟
مناسب برای جداسازی، غنیسازی و شمارش باکتریهای رودهای از جمله Escherichia coli و سایر کولفرمها است.
2. روش آمادهسازی EC broth چگونه است؟
پودر را در آب حل کنید، حرارت دهید تا حل شود و سپس طبق پروتکل آزمایشگاهی استفاده کنید؛ اتوکلاو بعد از حل اختیاری است.
3. این محیط کشت چه ویژگی انتخابپذیری دارد؟
دارای نمکهای صفراوی است که رشد باکتریهای گرم مثبت و غیر رودهای را مهار میکند و رشد کولفرمها و E. coli را تشویق میکند.
4. مدت زمان رشد و دما برای E. coli چقدر است؟
رشد معمولا 24 ± 2 ساعت در 44 ± 1°C انجام میشود و سایر کولفرمها ممکن است تا 48 ساعت نیاز داشته باشند.
5. چگونه باید EC broth را ذخیره کرد؟
در محیط خشک و بسته نگه دارید و دما بین 15–25°C باشد تا کیفیت محیط حفظ شود.
6. آیا EC broth برای استفاده در صنایع غذایی مناسب است؟
بله، برای غذا، آب، خوراک دام و محصولات مرتبط مناسب است و در کنترل کیفیت میکروبی کاربرد دارد.
7. آیا این محیط کشت شامل شاخص افتراقی است؟
خیر، این محیط انتخابی ولی غیر افتراقی است و برای تشخیص ایمنی و شمارش E. coli طراحی شده است.

هنوز نظری ثبت نشده
اولین نفری باشید که نظر میدهید
ثبت نظر